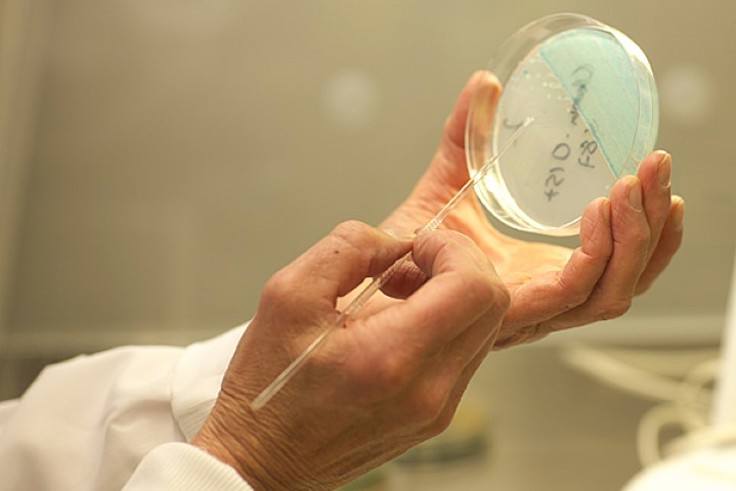

AMR-senterets aktiviteter
Artikkel
|Sist endret
Vår forskning er sentrert rundt AMR-emner som er relevante for folkehelsen, tett koblet med reelle utfordringer fra overvåkningssystemer og nasjonal epidemiologi.
Vi samarbeider tett både innad i og utenfor FHI for å takle oppgaver og utfordringer innenfor dette kritiske feltet. Senteret har som mål å omfatte all AMR-relatert og relevant forskning innen de forskjellige avdelingene på instituttet, for å fremme en helhetlig tilnærming til utfordringene med antibiotikaresistens.
Å posisjonere AMR-senteret ved FHI, som det fremste knutepunktet for AMR-forskning i Norge, er en strategisk målestokk. Vi forplikter oss til å være det naturlige kontaktpunktet for AMR-forskning, fremme samarbeid og aktivt bidra til det nasjonale forskningslandskapet.
Studere spredning av antimikrobiell resistens
Feltet dekker et bredt spekter med behov for kunnskap om genetisk mobilitet, spredning av resistens og studier av eksponeringsdata. Helgenomsekvensering, bioinformatikk og tolkning av metagenomdata vil bidra til å forstå hvordan gener forflytter seg mellom mikrober og individer. Utvikling av epidemiologiske modeller basert på disse dataene gjør det mulig å studere fenomener relatert til AMR, både på enkeltindividnivå og befolkningsnivå.
Stimulere til riktig bruk og redusere resistensutvikling
For å sikre riktig behandling av personer som trenger det og redusere resistensutvikling, er senteret engasjert i forskning og helseanalyser om hvordan behovet for antibiotika kan reduseres gjennom bedre smittevern, infeksjonsforebygging og ved å hindre smitte med resistente mikrober. Gode overvåkingssystemer som både inkluderer bruks- og resistensdata hos mennesker og dyr er grunnleggende for å dokumentere og måle dagens situasjon og fremgang.
FHI har bygget sterk kompetanse og renommé på spesifikke policyrelaterte områder som smittevern, innovasjon og tilgang. Her fremmer fagmiljøer på FHI kunnskap om riktig bruk av antibiotika, samfunnsøkonomiske konsekvenser, samt kunnskap om virkemidler og faktorer som påvirker tilgang til og innovasjon på antibiotika.
Studere eksponeringsdata og kartlegge genetisk profil til bakteriene
FHI har moderne fasiliteter og sterke fagmiljøer som arbeider med å studere antimikrobielle eksponeringssdata og kartlegging av genetisk profil til bakterier og deres resistensmekanismer. Dette muliggjør bedre identifikasjon og forståelse av resistens og resistensspredning hos mikrober. Forskning på resistom- og metagenomdata gir økt innsikt i mikrobiell økologi og øker forståelsen for resistensutvikling som skyldes mobile genetiske elementer og seleksjonspress. Kobling av NGS-data med andre typer av data slik som bruk av smittevern, antibiotika, miljøfaktorer, reisevirksomhet og kosthold kan lede til bedre innsikt og effektive intervensjoner.
Effekt av intervensjoner på folkehelsenivå
Senter for AMR har et sterkt fokus på policynivåbasert på forskning og kunnskapsformidling av høy kvalitet. Kobling av kunnskap og forskning fra ulike deler av AMR-området er viktig for å kunne gi gode kunnskapsbaserte råd til helsevesen og myndigheter. Målet er å bedre pasientenes helse- og omsorgstjenester, gi bedre kvalitet og pasientsikkerhet samt bidra til godt folkehelsearbeid på området.
Knutepunkt for AMR-forskning
Å posisjonere AMR-senteret ved FHI som det fremste knutepunktet for folkehelserelevant AMR-forskning i Norge er en strategisk målestokk. Vi forplikter oss til å være det naturlige kontaktpunktet for AMR-forskning på FHI, fremme samarbeid og aktivt bidra til det nasjonale og internasjonale arbeidet på feltet.
Senterets medlemmer er aktive i å dele våre mål og erfaringer i nasjonale og internasjonale fora, slik som i TATFAR, NDPHS og NORSE.